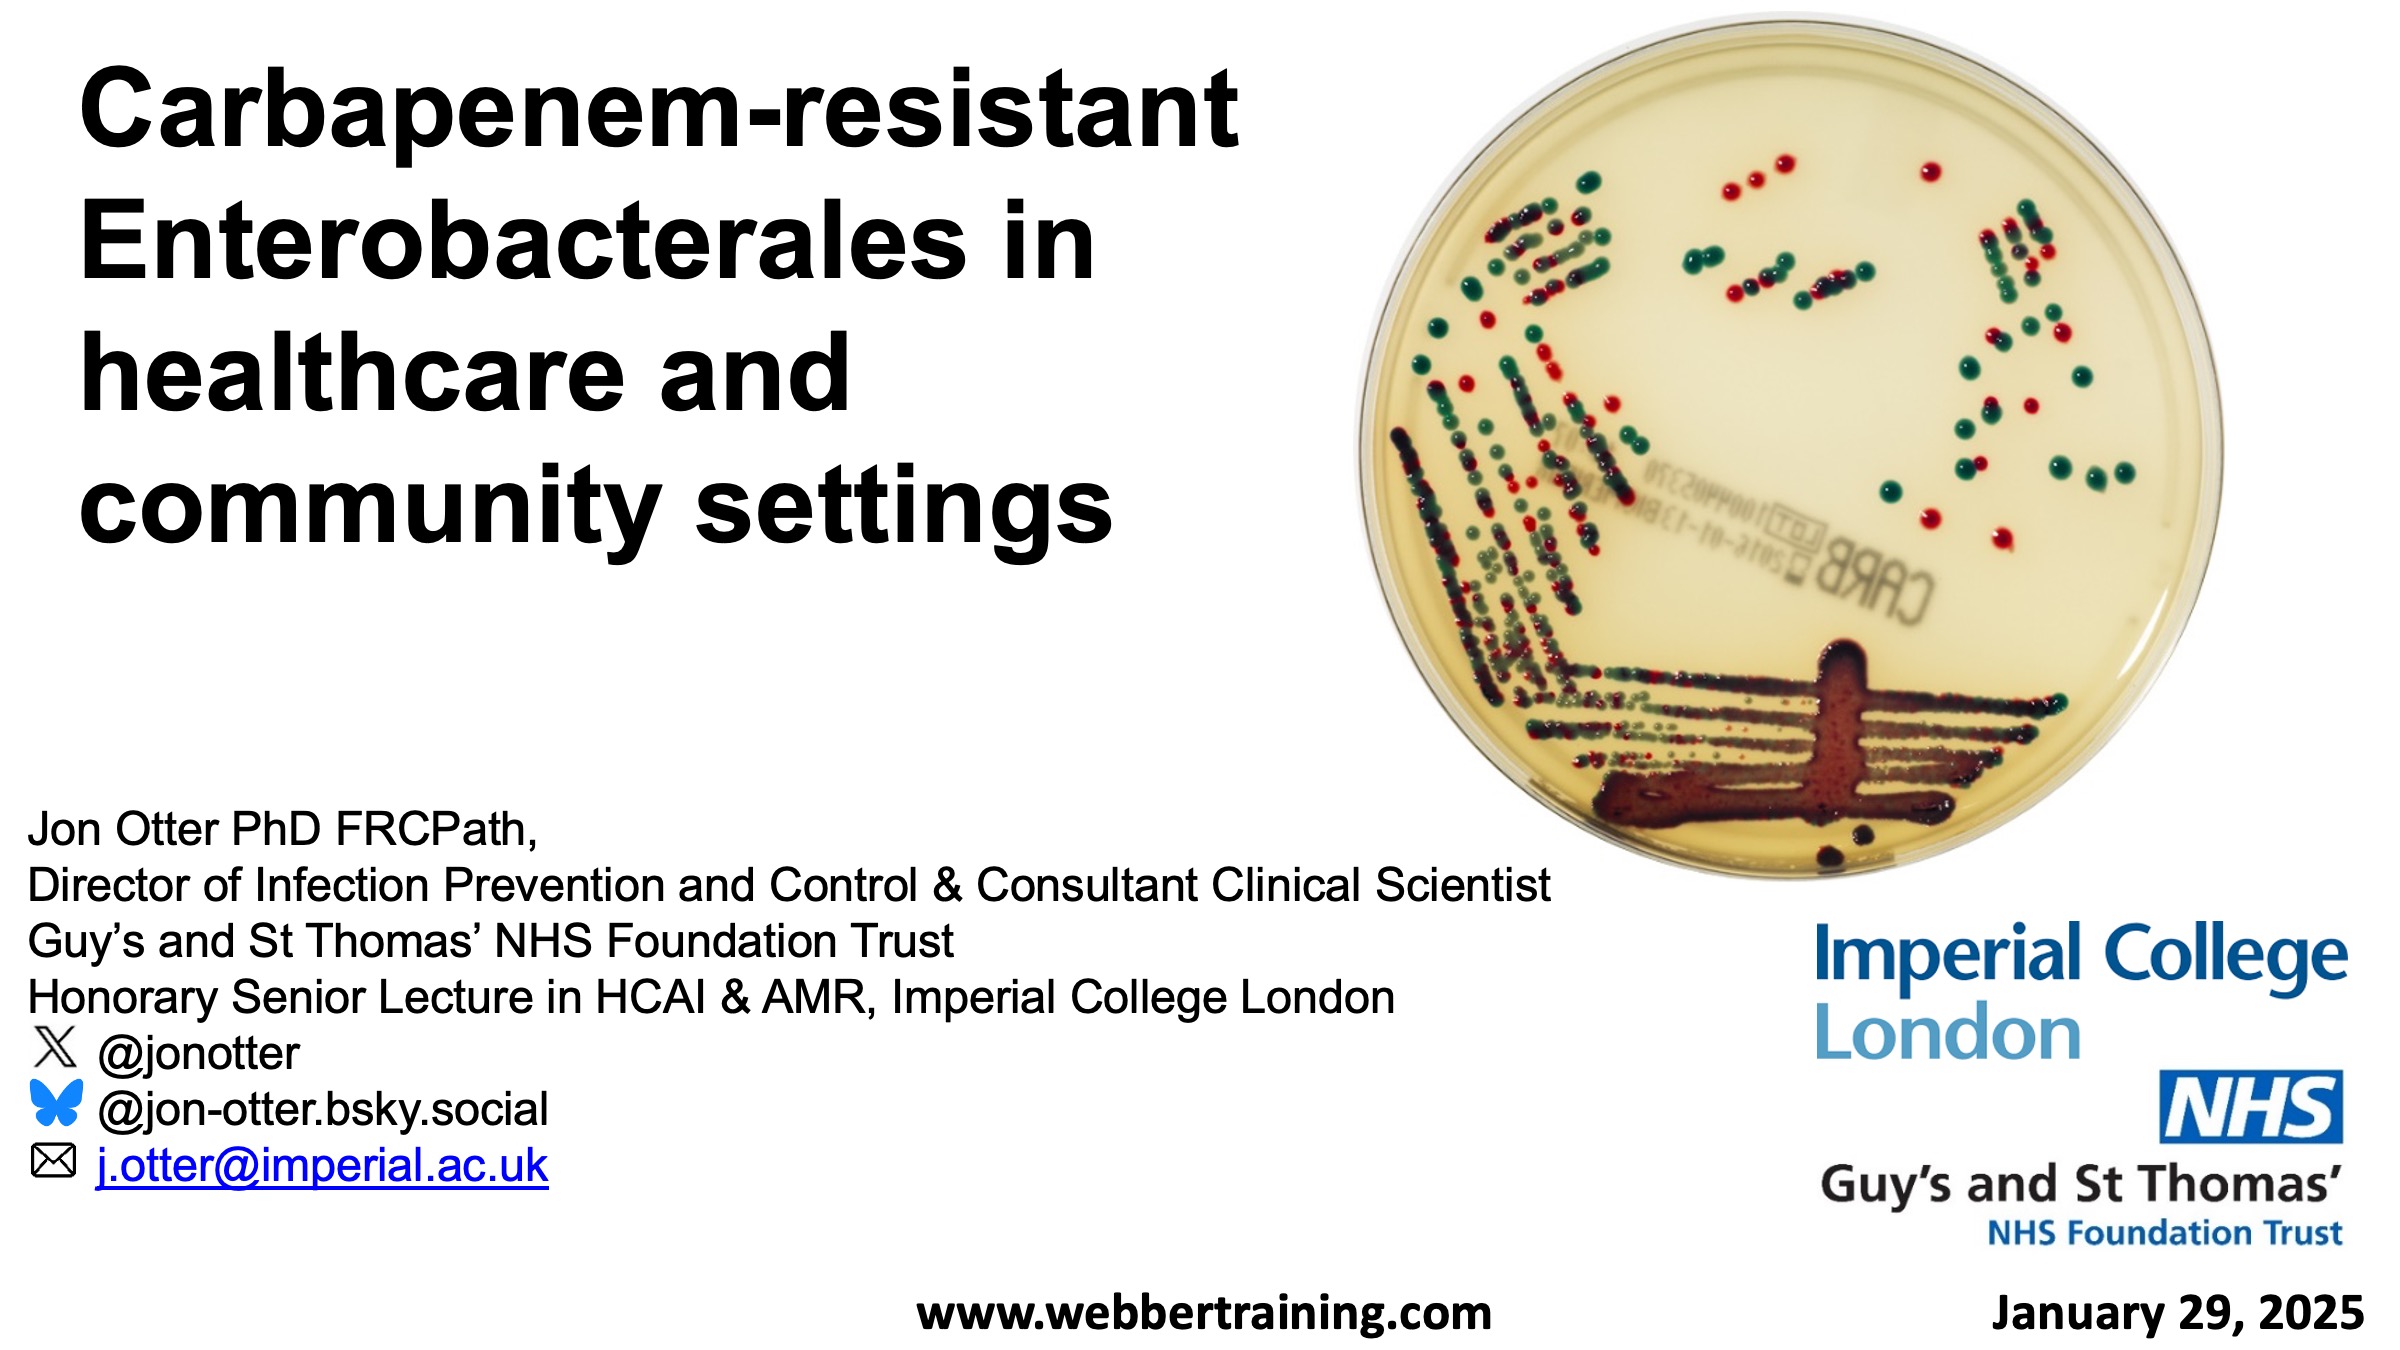

Events
-
-

-
Carbapenem-Resistant Enterobacterales in Healthcare and Community Settings
Prof. Jon Otter, Imperial College London
-
-

Is LTC Prepared for the Next Pandemic?
Dr. James Ayukekbong, Editor-in-Chief, Canadian Journal of Infection Control
Free -

(Australasian Teleclass) Gloves Off – A Quality Improvement Project
Australasian Teleclass
Patricia Knight and Dr. Sarah Browning, John Hunter Hospital Campus, AustraliaFree -

-
-

Practical Approaches in a Catastrophe – The Defunding of Aid Projects
Professor Francois Venter, University of the Witwatersrand, South Africa
Free -

The Perfect Predator – A Scientist’s Race to Save Her Husband From a Deadly Superbug
Prof. Steffanie Strathdee, Center for Innovative Phage Applications & Therapeutics (IPATH)
Free -

Antibiotic Stewardship Synergy with Infection Prevention and Control to Combat AMR: “The Dream Team”
Presented by the International Federation of Infection Control (IFIC)
Professor Bradley Langford, Dala Lama School of Public Health, University of TorontoFree -

HIV 2026: Everything You Wanted to Know on Prevention, Transmission, Treatment and the Future
Professor Francois Venter, University of the Witwatersrand, South Africa
Free -

The Built Environment Infection Prevention Initiative (BEIPI): The Role of a Multi-Disciplinary Team in Building Safer Hospitals
Presented by the Healthcare Infection Society (HIS)
Dr. Michael Weibren, Sherwood Forest NHS Trust, and Dr. Manjula Meda, University of SurreyFree -
-

An Overview of the Leapfrog Group’s Hand Hygiene Standard
Time Zone: New York / Toronto
Prof. Matt Austin and Preeti Joshi, Johns Hopkins School of MedicineFree -

Is Infection Prevention and Control Guidance Fit for People? The Case for Compassionate, Person-Centred IPC
Jules Storr, S3 Global Healthcare
Free -

New WHO/UNICEF Global Guidelines on Hand Hygiene in Community Settings
Presented by the International Federation of Infection Control (IFIC)
Joanna Esteves Mills, World Health OrganisationFree -
-

5 May World Hand Hygiene Day – Action Saves Lives
Miranda Deeves, WHO Technical Officer, Infection Prevention and Control, and Claire Kilpatrick, WHO consultant, Infection Prevention & Control
Free -

Publish or Perish! How and Why You Should Publish Articles in Academic Journals
Presented by the International Federation of Infection Control (IFIC)
Martin McDonald, Journal of Hospital Infection and Infection Prevention in PracticeFree -

Patient Safety Begins at the Front Door: Infection Prevention in Home Health & Hospice
Mary McGoldrick, Home Health Systems Inc
Free -

(IPAC Canada conference broadcast) Environmental Stewardship in IPAC
Dr. Fiona Miller, Professor and Director, Collaborative Centre for Climate, Health &
Sustainable Care, University of Toronto, and Director, CASCADESFree -

(IPAC Canada conference broadcast) Misinformation and Disinformation: The Next Pandemic
Craig Silverman, Journalist
Free -
-

(Australasian Teleclass) Infection Prevention and Control Response and Escalation Framework: Evaluation and Application Beyond a Pandemic
Australasian Teleclass
Kathy Dempsey, Clinical Excellence Commission, AustraliaFree -

Monitoring and Evaluation to Optimize Microbiology and Care
Prof. Prameet Sheth, Queen’s University, Canada
Free -

The Role of the Environment in the Transmission of Infection – How Can We Intervene?
An International Federation of Infection Control (IFIC) teleclass
Prof. Elaine Cloutman-Green, Great Ormond Street Hospital, UKFree -
-

Mycobacterium tuberculosis Transmission in Healthcare Settings
Prof. Michael Klompas, Harvard University
Free -

LTC Preparedness for the Next Pandemic Part 2 – Getting Ready
Dr. James Ayukekbong, Editor-in-Chief, Canadian Journal of Infection Control
Free -

National and Local IPC Improvement Steps – What it Takes for Success
Presented by the International Federation of Infection Control (IFIC)
Dhouha Ammar Hamdani and Dr. Ali Jameela, Ministry of Health, QatarFree

